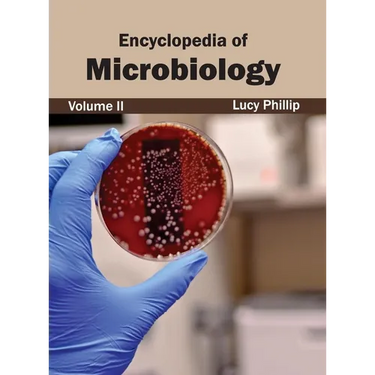
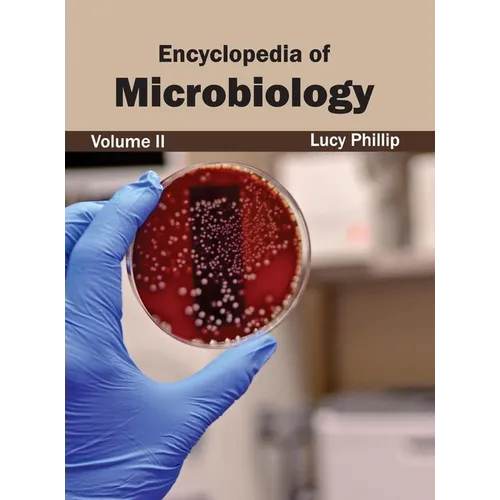

Encyclopedia of Microbiology: Volume II - Hardcover
Encyclopedia of Microbiology: Volume II - Hardcover
$196.00
/

products.product.pickup_availability.unavailable
Your payment information is processed securely. We do not store credit card details nor have access to your credit card information.
by Lucy Phillip (Editor)
This book attempts to understand the science of microbiology. The current research and data available in this field are discussed, and the ramifications of advancements in this arena are also included. The various branches that microbiology overlaps with or that shoot out from it are glanced at with research and future opportunities for progress. Researchers and students of this field will be assisted by this book. It will help them in increasing their expertise by helping them keep up with the rapid changes in microbiology.